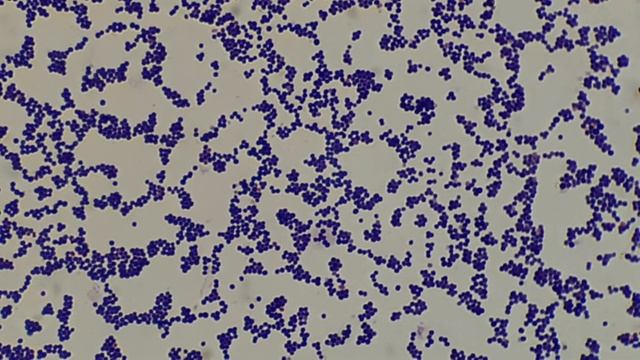

Автор / Канал: Путешествия с Друзьями на Лапках Страница 6
Bacteria under the Microscope/Staphylococcus/ Gram Positive Cocci

Спасаем детёныша Куницы.

Фазани...

19 дней джунгарским хомичкам. Мама Соня детак 6 - тира

Выбираем рептилию в зоомагазине: хамелеон или черепаха?

#животные #рек #киса

Виктор Чижиков. Мужик и медведь. Русская народная сказка

Каких размеров бывает живец для щуки

Кулик-перевозчик

ЛИ СЯО. Алиса - Лиса. Про домашних лис.

Поход на гору Малый Иремель.

Какаду кукушечка говорит

?Звуки Морских Животных?. Играем вместе. Игрушки и игры с детьми.

как будет серая птица на китайском?

Why does a Cuckoo bird lay eggs on a nest of crows?

Подводная Охота - Как найти Карпа в пруду! 4 Простых и Эффективных совета для Начинающих и Опытных

Рождество и красный кардинал??Vlogmas

⭐Водительские перчатки | Гремучая змея

Пряники собачки расписные

Собака похожая на медведя

Фантастические существа из Хроники Нарнии. Сравнение их с мифологическими собратьями

Енот плавает

КАМЕЛИИ И ЭЛЬФЫ ? ЗИМА В АЛАБАМЕ. СУБТРОПИКИ.

Илья Лагутенко и группа Горностай - Бархатный сезон
За каждым успешным каналом стоит личность, идея и сотни часов кропотливого труда. Если вы здесь, значит, автор «Путешествия с Друзьями на Лапках» уже сумел зацепить ваше внимание своим уникальным стилем или подачей. А мы на RUVIDEO позаботились о том, чтобы вы могли изучить весь архив его работ в максимально комфортных условиях — без лишней суеты и преград.
Почему за работами канала «Путешествия с Друзьями на Лапках» так интересно наблюдать? Всё просто: это честный контент, который находит отклик в сердцах зрителей. На нашем ресурсе вы можете смотреть онлайн все видео любимого автора бесплатно и в хорошем качестве. Нам важно, чтобы вы видели каждую деталь и слышали каждый нюанс, поэтому мы используем только стабильные плееры из открытых источников Rutube.
Следите за новинками канала, пересматривайте старые шедевры и открывайте для себя новые грани творчества «Путешествия с Друзьями на Лапках». Мы постоянно обновляем ленту, чтобы у вас под рукой всегда были самые свежие выпуски. Никаких сложных регистраций — только вы и творчество, которое вдохновляет. Приятного вам путешествия по миру авторского контента на RUVIDEO!
Видео взято из открытых источников Rutube. Если вы правообладатель, обратитесь к первоисточнику.